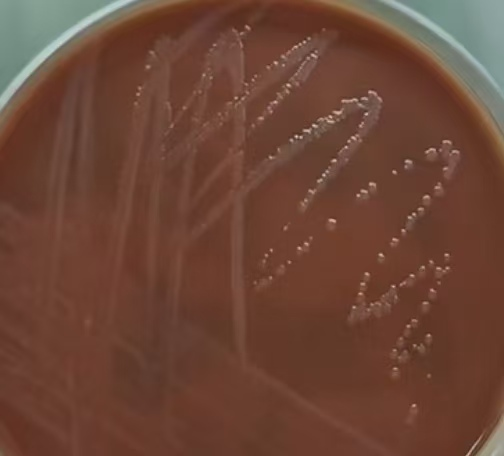

在性传播疾病领域中,淋病因其隐蔽性和危害性被称为“沉默杀手”。作为全球第二大性传播疾病病原体,50%的淋病感染者都无明显症状,但其潜在危害可能导致生育力受损甚至全身感染。玉溪市中山医院医学检验科为您详细解读淋病防治要点,帮助大众科学认识和防范这一隐形健康威胁。
什么是淋病?
淋病是由淋病奈瑟菌(简称淋球菌)引起的性传播疾病,主要通过性接触传播,也可通过接触被污染的物品间接感染,但后者较为罕见。淋病不仅影响泌尿生殖系统,还可能波及眼部、咽喉等部位。

▲显微镜下经革兰染色的淋球菌
表现症状
淋球菌感染潜伏期为2-10天,症状因性别和感染部位而异。男性多表现为尿道口红肿、流脓、尿痛,若感染上行可引发附睾炎;女性症状相对隐匿,常见白带异常、外阴瘙痒,上行感染易致输卵管炎,进而造成不孕。若眼部感染则会引发结膜炎,咽喉感染则出现吞咽困难等症状。
主要传播途径
1.性接触是淋病最主要的传播途径。高危人群:性活跃期的青壮年、有多个性伴侣以及未使用安全套的人群感染风险较高。
2.母婴传播:孕妇感染淋球菌可能导致流产,新生儿还可能患上结膜炎(严重者失明)
3.间接接触传播:由于淋球菌离体后迅速死亡,间接传播概率极低,但共用毛巾、浴盆等仍可能感染。
针对淋病检测,玉溪市中山医院医学检验科开展了两种检测淋球菌的方法和外送大玉医的检测方法:
1. 涂片镜检:该方法具有快速、低成本的优点,通过采取尿道或宫颈分泌物进行革兰染色后镜检来判断是否感染。但需要注意的是,这种方法对女性患者的漏检率较高。


▲革兰染色后显微镜下见白细胞内外革兰阴性双球菌
2. 淋球菌培养:在5%CO₂环境下,使用专用巧克力培养基培养48小时,会形成类似露滴状的菌落。此方法是诊断淋病的金标准,还可以同时进行抗菌药物敏感性试验,不过耗时较长。
▲淋球菌在培养基上的菌落形态
3.核酸检测(外送大玉医):该检测方法的灵敏度超过98%,能够快速准确地检测出淋球菌的核酸,非常适合早期诊断和无症状感染者的筛查,只是费用相对较高。
淋病预防措施
1.坚持安全性行为,正确使用安全套。有不洁性行为史的人群,即使没有出现明显症状,也应主动进行筛查。
2.避免与他人共用个人卫生用品。
3.高危人群要定期进行性病筛查。
4.一旦确诊淋病,应立即进行规范治疗,建议性伴侣同步接受检测和治疗,在治疗过程中必须严格遵循医嘱,足量用药并定期复查,切勿自行停药。
5.增加对性病防治知识的了解,提高自我保护意识。
淋病作为危害隐蔽的性传播疾病,其潜伏的健康威胁不容忽视。但只要在日常生活中做到早筛查、早诊断、早治疗,同时做到科学的预防,完全能够阻断其传播链条。玉溪市中山医院医学检验科始终致力于医学科普工作,在此特别提醒大众不必“谈性色变”,应打破认知误区,主动了解淋病等性传播疾病的防治知识,既是对自身健康的负责,更是对家人的守护。